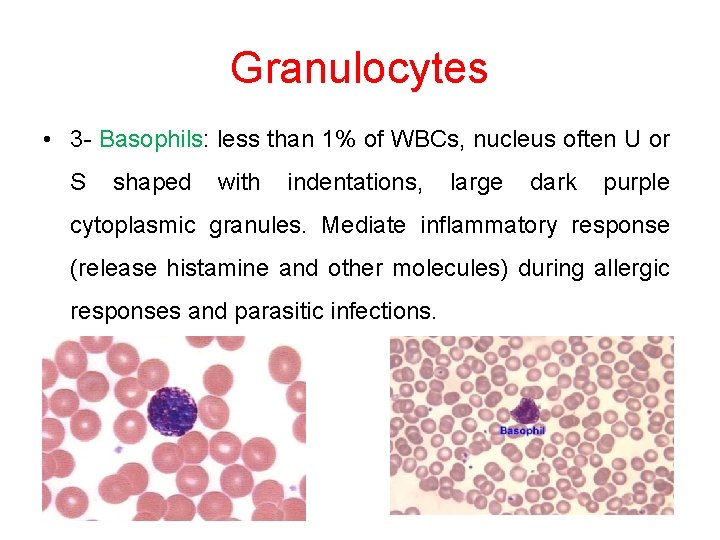
Granulocytes • 3 - Basophils: less than 1% of WBCs, nucleus often U or

Peripheral Blood Film The Differential Leukocyte Count DLC

Peripheral Blood Film The Differential Leukocyte Count (DLC) Physiology Lab-2 October 2017

Peripheral Blood Film The Differential Leukocyte Count (DLC) Definition: Blood film or peripheral blood smear is a thin layer of blood smeared on a slide and then stained in such a way to allow the various blood cells to be examined microscopically. A blood smear is a blood test that gives information about the number and shape of blood cells. The cell types are examined under a microscope to investigate hematological problems (disorders of the blood) Goals: • The student will prepare a blood smear which is even, smooth and have an acceptable feathered edge. • To become familiar with the various types of white blood cells

Applications of Blood smear: • to detect infection or inflammation, determine the effects of possible poisoning by chemicals, drugs, chemotherapy, radiation, etc. • DLC is also done to monitor blood diseases like leukemia, or to detect allergic and parasitic infections. • The determination of each type of WBC helps in diagnosing the condition because a particular type may show an increase or decrease.

Background • There are three main cells within the blood that the test focuses on: red cells: (which carry oxygen throughout the body) white cells: (which function as part of the body’s immune system) Platelets: (which are important for blood clotting).

Types Of WBCs • Granulocytes are larger than RBCs and have lobed nuclei and granules in their cytoplasm. • Neutrophils • Eosinophils • Basophils

Granulocytes • 1 -Neutrophils: 40 -70% of WBCs, 3 -7 lobed nucleus, pale lilac or pink cytoplasm contains very fine granules which are difficult to see. They are active phagocytes and fight bacterial invasions (important in inflammatory response) as well as cleaning up debris.

Granulocytes 2 -Eosinophils: 1 -4% of WBCs, bilobed nucleus, large red/orange cytoplasmic granules. Important in ending allergic reactions (phagocytize antibody-bound allergens) and fighting parasitic worms.
Granulocytes • 3 - Basophils: less than 1% of WBCs, nucleus often U or S shaped with indentations, large dark purple cytoplasmic granules. Mediate inflammatory response (release histamine and other molecules) during allergic responses and parasitic infections.

Types Of WBCs • Agranulocytes have no observable granules and nuclei are usually roughly spherical. • Lymphocytes • Monocytes

Agranulocytes • 1 -Lymphocytes: 20 -40% of WBCs, about the size of a RBC, dark blue or purple nucleus, sparse gray/blue cytoplasm. Important role in immune system.

Agranulocytes • 2 - Monocytes: 4 -8% of WBCs, largest of the WBCs, dark blue nucleus, abundant gray/blue cytoplasm. They are active phagocytes and considered important in longterm clean up.

Materials and instruments 1 -Whole blood using EDTA as anticoagulant or capillary blood drawn from a finger or toe puncture. 2 - Glass slide 3 - Microscope 4 - Alcohol 70% 5 - Lancet 6 - Leishman's stain Leishman’s stain: It is probably one of the simplest and most precise methods of staining blood for diagnostic purposes. It contains a compound dye—eosinate of methylene-blue dissolved in acetone-free methyl alcohol.

• i. Eosin. It is an acidic dye (negatively charged) and stains basic (positive) particles—granules of eosinophils, and RBCs a pink color. • ii. Methylene-blue. It is a basic dye (positively charged) and stains acidic (negatively charged) granules in the cytoplasm, nuclei of leukocytes, especially the granules of basophils, a blue-violet color. • iii. Acetone-free and water-free absolute methyl alcohol. The methyl alcohol is a fixative and must be free from acetone and water. It serves two functions: • a. It fixes the blood smear to the glass slide. The alcohol precipitates the plasma proteins, which then act as a ‘glue’ which attaches (fixes) the blood cells to the slide so that they are not washed away during staining. • b. The alcohol preserves the morphology and chemical status of the cells.

Identifying a Leukocyte • . A leukocyte is identified from its size, its nucleus, and the cytoplasm—its color, whether vesicles (granules) are visible or not, their color and size if visible, and the cytoplasm/nucleus ratio.

• Procedure • Prepare the blood smear • Clean two slide, one to be covered with the blood film and one to be used as spreader. • Clean the finger with alcohol, allow it to dry and then prick it with a disposable lancet to obtain a drop of blood. • Make a fine touch of one end of a slide with the drop of blood. • Place the edge of the other slide on the surface of the first slide just in front of the drop of blood and at an angle of 45˚. • Draw the spreader back until it makes contact with the drop of blood. • Push the spreader slowly and smoothly to the other end of the slide. • Allow the film to dry at room temperature. • They should be also labeled immediately with the student's name and the date at the end of slide.

– Staining the blood smear by: – Put the dried slide on a staining rack. – The blood smear should be stained as soon as possible certainly within 1 to 2 hours. • Carefully drop Leishman's stain onto the blood film until the film is covered – Allow the stain to act for one to two minutes. – Add distilled water to the stain, this gives dilution of 1: 1 or 1: 2 – The diluted stain should act for 15 -30 minutes – Then wash it off with distilled water, continue washing until the film has a pink color. – Shake off excess water and allow it to dry at room temperature. – Examination of the stained smear under the microscope.

Calculation • Count each WBC seen and record on a differential cell counter until 100 WBCs have been counted. For instance if 25 of the 100 WBCs where lymphocytes, then the percentage of lymphocytes is 25%. • The normal range percentage of the different types of WBCs is as follows: Neutrophils 50 -70% Eosinophils 1 -4% Basophils 0. 4% Monocytes 2 -8% Lymphocytes 20 -40%


WBC type high count may indicate low count may indicate Neutrophils bacterial infection, burns, stress, inflammation radiation exposure, drug toxicity, vitamin B 12 deficiency, systemic lupus erythematosus (SLE) Eosinophils allergic reactions, drug toxicity, stress parasitic infections, autoimmune diseases Basophils allergic reactions, leukemias, cancers, hypothyroidism pregnancy, ovulation, stress, hyperthyroidism Lymphocytes viral infections, some leukemias, Bacterial infections. prolonged illness, radiation. AIDS, immunosuppressio n, treatment with cortisol Monocytes viral or fungal infections, tuberculosis, some leukemias, other chronic diseases bone marrow suppression, treatment with cortisol

Thank you
- Slides: 20